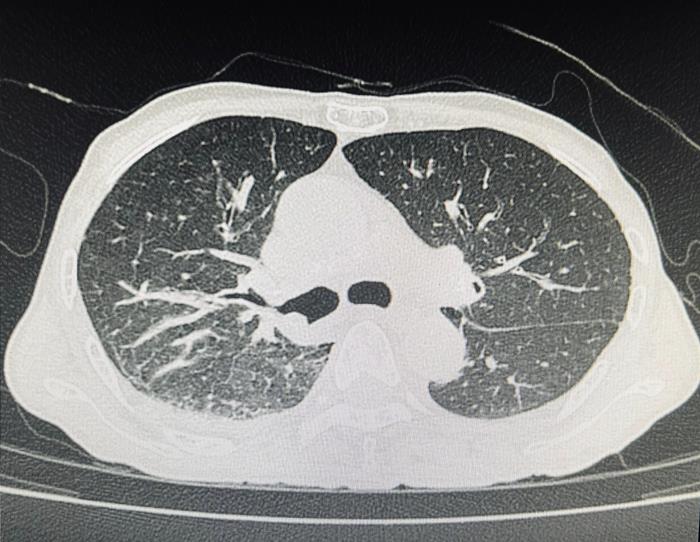
หลอดลมดำ ผลจากการเผา สูดควัน

เปิดเคสคนไข้วัย 70 มาด้วยอาการไอ เสมหะเป็นเลือด เอกซเรย์ปอดเจอก้อน หมอขอเช็กให้ชัวร์ด้วยการส่องหลอดลมก็ช็อกทันที พบหลอดลมดำมาก และก็ยังไม่รู้ว่าเป็นมะเร็งไหม ผลจากการทำงานสูดควันดำมาตลอด แม้จะหยุดสูบบุหรี่มา 20 ปีแล้วก็ตาม
ปัญหาฝุ่น PM2.5 กลายเป็นปัญหาเรื้อรังที่กลายเป็นวาระสำคัญของประเทศเป็นลำดับต้น ๆ ไปแล้ว เพราะปัญหานี้ส่งผลต่อสุขภาพประชาชนโดยตรง ทำให้เสี่ยงเป็นโรคมะเร็งปอดหรือโรคเกี่ยวกับทางเดินหายใจ ซึ่งเรื่องนี้ต้องได้รับการแก้ไขอย่างเร่งด่วน
ล่าสุด วันที่ 16 ธันวาคม 2566 เฟซบุ๊ก Nuttagarn Chuenchom ของ พญ.ณัฐกานต์ ชื่นชม จาก รพ.แม่สอด จ.ตาก มีการโพสต์เคสที่น่าสนใจและเจอได้ไม่บ่อยนัก เกี่ยวกับโรคมะเร็งปอดรวมถึงหลอดลม มีรายละเอียดดังนี้
ผู้ป่วยรายนี้เป็นเพศชาย วัย 70 ปี มาด้วยอาการไอเรื้อรัง มีเสมหะปนเลือด หอบเหนื่อยจนเดินไม่ค่อยไหว ผอมจนน้ำหนักลด เมื่อเอกซเรย์ตรวจดู พบว่า มีลักษณะคล้ายปอดอักเสบที่ด้านขวาล่างหรือมีอะไรที่คล้ายก้อนมะเร็งอยู่ตรงนั้น
จากนั้น
แพทย์จึงตรวจสอบเชิงลึกโดยใช้วิธีส่องกล้องเข้าไปดูผ่านทางเดินหายใจ
กลับพบสิ่งที่น่าตระหนกกว่า คือ หลอดลมคนไข้รายนี้เป็นสีดำทั่ว ๆ
กระจายเป็นหย่อม ๆ หมอก็ไม่เคยเจอเคสแบบนี้ ดังนั้น
จึงมีการสอบถามประวัติคนไข้เพิ่มเติม พบว่า ผู้ป่วยรายนี้หยุดสูบบุหรี่กว่า
20 ปี แต่มีอาชีพทำไร่ทำสวน สัมผัสฝุ่นควันและมลภาวะเป็นเวลานาน
ฝุ่นถ่านดำเข้ามาในหลอดลม จนเกิดพังผืดและหลอดตีบ
ลามไปสู่เรื่องของปอดติดเชื้อ ปอดอักเสบเนื่องจากการอุดกั้น
เกิดปอดแฟบอย่างที่เห็นในฟิล์มที่คล้ายลักษณะก้อน ๆ
ส่วนสาเหตุที่ไอเรื้อรัง หอบเหนื่อย เพราะหลอดลมและเนื้อปอดผิดปกติ ถ้าเป็นหนักมาก ๆ คือ ฝุ่นถ่านดำจะโดนเนื้อปอดด้วย เรียกว่า โรคปอดถ่านหิน และยังสัมพันธ์กับวัณโรคได้ 20% และเป็นโรคมะเร็งได้ 10%
ตอนนี้รอผลตรวจน้ำล้างของปอดคนไข้ก่อน ยังไม่ตัดชิ้นเนื้อเพราะหาก้อนไม่เจอ ส่วนการรักษาเบื้องต้นคือรักษาแบบโรคปอดอักเสบไปก่อน และเหตุการณ์นี้เตือนให้รู้ว่า ฝุ่นควันดำขนาดใหญ่มาก ๆ อาจทำให้เกิดหลอดลมหรือปอดพังได้
ปัญหาฝุ่น PM2.5 กลายเป็นปัญหาเรื้อรังที่กลายเป็นวาระสำคัญของประเทศเป็นลำดับต้น ๆ ไปแล้ว เพราะปัญหานี้ส่งผลต่อสุขภาพประชาชนโดยตรง ทำให้เสี่ยงเป็นโรคมะเร็งปอดหรือโรคเกี่ยวกับทางเดินหายใจ ซึ่งเรื่องนี้ต้องได้รับการแก้ไขอย่างเร่งด่วน
ล่าสุด วันที่ 16 ธันวาคม 2566 เฟซบุ๊ก Nuttagarn Chuenchom ของ พญ.ณัฐกานต์ ชื่นชม จาก รพ.แม่สอด จ.ตาก มีการโพสต์เคสที่น่าสนใจและเจอได้ไม่บ่อยนัก เกี่ยวกับโรคมะเร็งปอดรวมถึงหลอดลม มีรายละเอียดดังนี้
ผู้ป่วยรายนี้เป็นเพศชาย วัย 70 ปี มาด้วยอาการไอเรื้อรัง มีเสมหะปนเลือด หอบเหนื่อยจนเดินไม่ค่อยไหว ผอมจนน้ำหนักลด เมื่อเอกซเรย์ตรวจดู พบว่า มีลักษณะคล้ายปอดอักเสบที่ด้านขวาล่างหรือมีอะไรที่คล้ายก้อนมะเร็งอยู่ตรงนั้น
ส่วนสาเหตุที่ไอเรื้อรัง หอบเหนื่อย เพราะหลอดลมและเนื้อปอดผิดปกติ ถ้าเป็นหนักมาก ๆ คือ ฝุ่นถ่านดำจะโดนเนื้อปอดด้วย เรียกว่า โรคปอดถ่านหิน และยังสัมพันธ์กับวัณโรคได้ 20% และเป็นโรคมะเร็งได้ 10%
ตอนนี้รอผลตรวจน้ำล้างของปอดคนไข้ก่อน ยังไม่ตัดชิ้นเนื้อเพราะหาก้อนไม่เจอ ส่วนการรักษาเบื้องต้นคือรักษาแบบโรคปอดอักเสบไปก่อน และเหตุการณ์นี้เตือนให้รู้ว่า ฝุ่นควันดำขนาดใหญ่มาก ๆ อาจทำให้เกิดหลอดลมหรือปอดพังได้